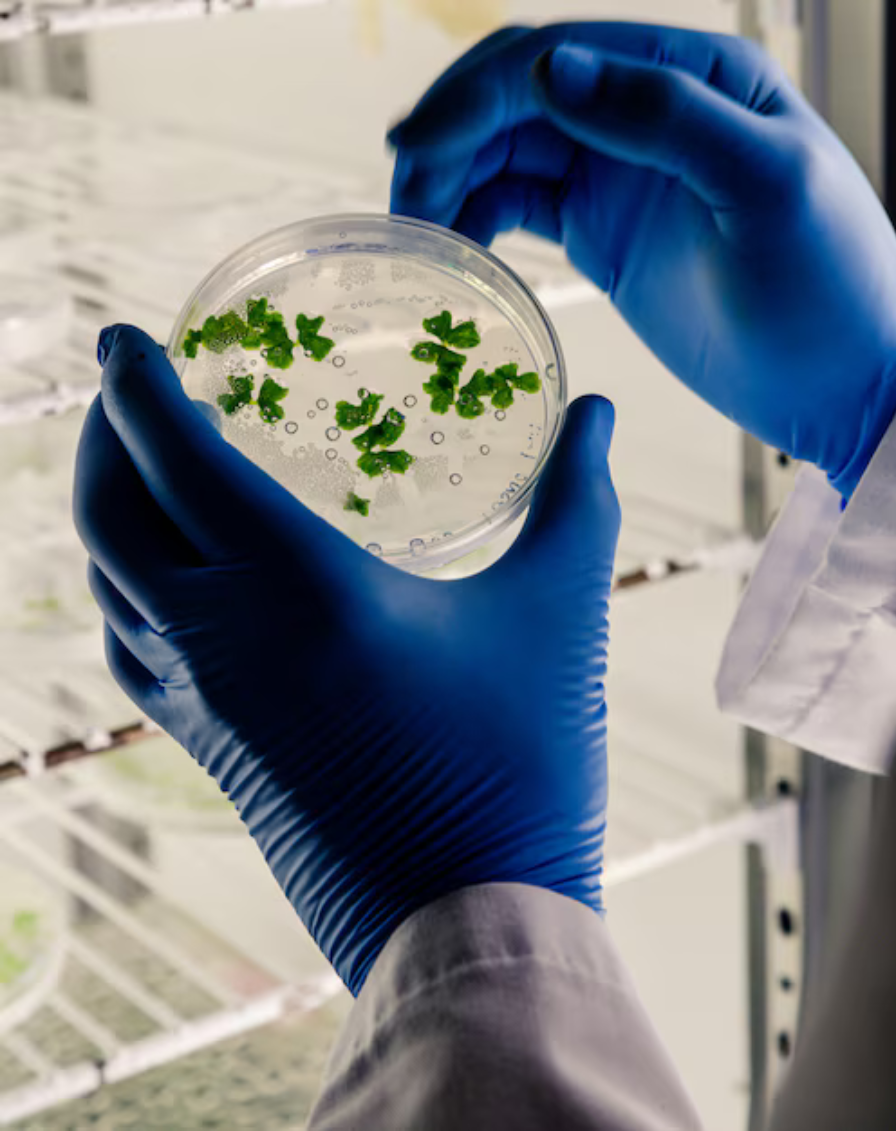
about-img

Designed to target E. coli infections, its engineered bacteriophage work to precisely remove E. coli
bacteria in patients with urinary tract infections (UTIs).
Worldwide, an estimated 150 million people are affected by UTls each year. Approximately 80
percent of these are caused by E. coli, often including difficult-to-treat strains that are resistant to
commonly used antibiotics. Nearly 40 percent of patients with UTIs experience a recurrence within
months of the first episode. Both the U.S. Centers for Disease Control and Prevention (CDC) and
World Health Organization (WHO) have identified antibiotic-resistant E. coli as an urgent and
serious public health threat requiring development of new treatments.
Our focus is to help resolve this challenge with our Precision Phage Therapy Initiative.

This is a precision medicine designed to target P. aeruginosa infections. It is an engineered
bacteriophage product to precisely remove P. aeruginosa bacteria in patients with pneumonia.
Hospital-acquired pneumonia (HAP) and ventilator-associated pneumonia (VAP) affect a combined
400,000 people per year in the US, with HAP affecting approximately 3-4 times more individuals
than VAP. Bacterial HAP/VAP often develops from gram negative organisms including P.
aeruginosa, with drug-resistant forms being of particular concern as they often lead to worse clinical
outcomes for impacted patients.
Our precision medicine designed to target S. aureus infections. It is an engineered bacteriophage
product, aiming to precisely remove S. aureus bacteria in patients with bloodstream infections
(BSIs).
BSIs affect approximately 250,000 people per year in the US. S. aureus is a leading cause of BSIs,
responsible for approximately 20–30% of all cases. Among these, MRSA is a particularly
problematic pathogen due to its resistance to multiple antibiotics.
These infections are associated with high morbidity and mortality, prolonged hospital stays, and
significant healthcare costs. Current standard-of-care antibiotics may be ineffective against resistant
strains, and broad-spectrum treatments can disrupt the patient microbiome. Our program seeks to
provide a targeted therapeutic option that selectively eliminates pathogenic bacteria while reducing
the pressure that drives further antimicrobial resistance and recurrence.





This is a precision medicine designed to target Klebsiella pneumoniae infections. It is an engineered
bacteriophage product to precisely remove K. pneumoniae bacteria in patients with complicated
UTIs.
There are 3–4 million complicated UTIs diagnosed in the US annually, which account for more than
$6 billion in healthcare costs.
Succor LLC works with partners to advance the development of this program. Our partners
accelerate global antibacterial innovation by supporting the development of new antibiotics and
other life-saving products to combat the most dangerous drug-resistant bacteria.
By selectively targeting K. pneumoniae, we aim to provide an effective, narrow-spectrum alternative
to broad-spectrum antibiotics, reduce recurrence rates, minimize disruption to the beneficial
microbiome, and address urgent unmet medical needs caused by multidrug-resistant infections. This
approach represents a critical advancement in precision medicine for complicated urinary tract
infections.

Adherent-invasive E. coli (AIEC) bacteria colonize the intestines of patients with Crohn’s disease,
driving a cycle of epithelial cell damage and inflammation that exacerbates the disease. Our program
is a precision medicine designed to eliminate AIEC bacteria and disrupt this cycle.
According to the Centers for Disease Control and Prevention, there are an estimated 3.1 million
adults in the US that have been diagnosed with inflammatory bowel disease (IBD). The majority of
IBD cases are either Crohn’s disease (1.3 million) or ulcerative colitis (1.6 million).
This program represents a novel approach to precision therapy by directly targeting pathogenic
bacteria while preserving beneficial gut microbiota. This targeted intervention has the potential to
reduce chronic inflammation, improve patient quality of life, and complement existing treatment
regimens, addressing a critical unmet need in managing Crohn’s disease.
